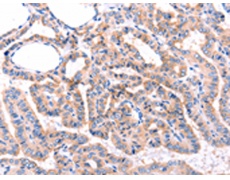
一抗

中文名稱: 兔抗GRK2多克隆抗體
|
Background: |
This gene encodes a member of the G protein-coupled receptor kinase family of proteins. The encoded protein phosphorylates the beta-adrenergic receptor as well as a wide range of other substrates including non-GPCR cell surface receptors, and cytoskeletal, mitochondrial, and transcription factor proteins. Data from rodent models supports a role for this gene in embryonic development, heart function and metabolism. Elevated expression of this gene has been observed in human patients with heart failure and Alzheimer's disease. |
|
Applications: |
ELISA, IHC |
|
Name of antibody: |
GRK2 |
|
Immunogen: |
Synthetic peptide of human GRK2 |
|
Full name: |
G protein-coupled receptor kinase 2 |
|
Synonyms: |
BARK1; ADRBK1; BETA-ARK1 |
|
SwissProt: |
P25098 |
|
ELISA Recommended dilution: |
1000-10000 |
|
IHC positive control: |
Human thyroid cancer |
|
IHC Recommend dilution: |
100-300 |

 購物車
購物車 幫助
幫助
 021-54845833/15800441009
021-54845833/15800441009